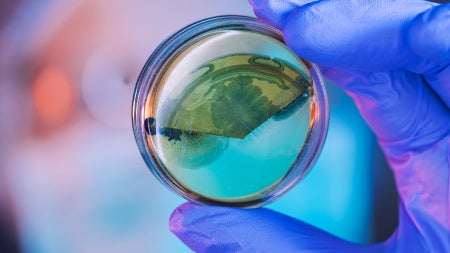
Bacteria

Results in mouse sepsis model lay foundation for clinical trials
Biochemists, microbiologists, drug discovery experts and infectious disease doctors have teamed up in a new study that shows antibiotics are not always necessary to cure sepsis in mice. Instead of killing causative bacteria with antibiotics, researchers treated infected mice with molecules that block toxin formation in bacteria. Every treated mouse survived. The breakthrough study, published in Scientific Reports, suggests infections in humans might be cured the same way. The molecules cling to a toxin-making protein found across Gram-positive bacterial species, called AgrA, rendering it ineffective. Treating mice with the therapeutic molecules effectively cured infections caused by methicillin-resistant Staphylococcus aureus (MRSA). S. aureus is notorious for its ability to overcome even the most potent antibiotics. Its resistance arsenal is broad, limiting therapeutic options to treat infections. In a mouse model of S. aureus sepsis, treatment with small molecules alone resulted in 100 percent survival, while 70 percent of untreated animals died. The small molecules were as effective in promoting survival as antibiotics currently used to treat S. aureus infections. The molecules also appear to give antibiotics a boost. Septic mice treated with a combination of the small molecules and antibiotics had 10x fewer bacteria in their bloodstream than mice treated with antibiotic alone. “For relatively healthy patients, such as athletes suffering from a MRSA infection, these molecules may be enough to clear an infection,” said Menachem Shoham, associate professor of biochemistry at Case Western Reserve University School of Medicine and senior author on the study. “For immunocompromised patients, combination therapy with the molecules and a low-dose antibiotic may be in order. The antibiotic in the combination could be one to which the bacteria are resistant in monotherapy, because our small molecules enhance the activity of conventional antibiotics, such as penicillin.” With support from the small molecules, previously obsolete antibiotics could reenter the clinic. Said Shoham: “This could provide a partial solution to the looming, global threat of antibiotic resistance.” If available, antibiotics kill most bacteria, but a small number of bacteria with natural resistance survive. Over time, antibiotic-resistant bacteria multiply and spread. By Centers for Disease Control and Prevention estimates, at least two million Americans get an antibiotic-resistant infection annually. For some infections, effective antibiotics are no longer available. Disarming bacteria of disease-causing toxins represents a promising alternative to dwindling antibiotics. Eliminating toxins frees up the immune system to eliminate bacterial pathogens instead of antibiotics, said Shoham, who also is affiliated with Q2 Pharma, Ltd., Haifa, Israel. “Without the toxins the bacteria become harmless. And since they don’t need the toxins to survive, there is less pressure to develop resistance.” The small molecules work against multiple bacterial species. The new study included preliminary experiments showing the molecules prevent three other bacterial species from killing immune cells. “These results indicate broad-spectrum efficacy against Gram-positive pathogens,” wrote the authors. Added Shoham: “We have proven efficacy not only against MRSA but also against Staphylococcus epidermidis, which is notorious for clogging catheters, Streptococcus pyogenes that causes strep throat, Streptococcus pneumoniae, and other pathogens.” Shoham led the study in collaboration with colleagues from the departments of biochemistry and dermatology and the Center for RNA and Therapeutics at Case Western Reserve University. The researchers developed two small molecules, F12 and F19, both of which potentiate antibiotic efficacy in the mouse models. The researchers are now working to commercialize both potential drugs. Case Western Reserve University has issued a license to Q2Pharma, Ltd., a biopharmaceutical startup company in Israel, to perform additional preclinical studies and develop F12 and F19 for clinical trials. Their initial trials will focus on patients suffering from systemic multi-drug resistant infections.This research was supported by a Transformational Award to Menachem Shoham by the Dr. Ralph and Marian Falk Medical Research Trust Bank of America, N.A., Trustee. Some in vitro studies were supported by NIH/NIAID Preclinical Services under contract numbers HHSN272201100012I and HHSN27200007. Greenberg, M, et al. “Small-molecule AgrA inhibitors F12 and F19 act as antivirulence agents against Gram-positive pathogens.” Scientific Reports. 2018 Oct 1;8(1):14578. doi: 10.1038/s41598-018-32829-w. PMID: 30275455.